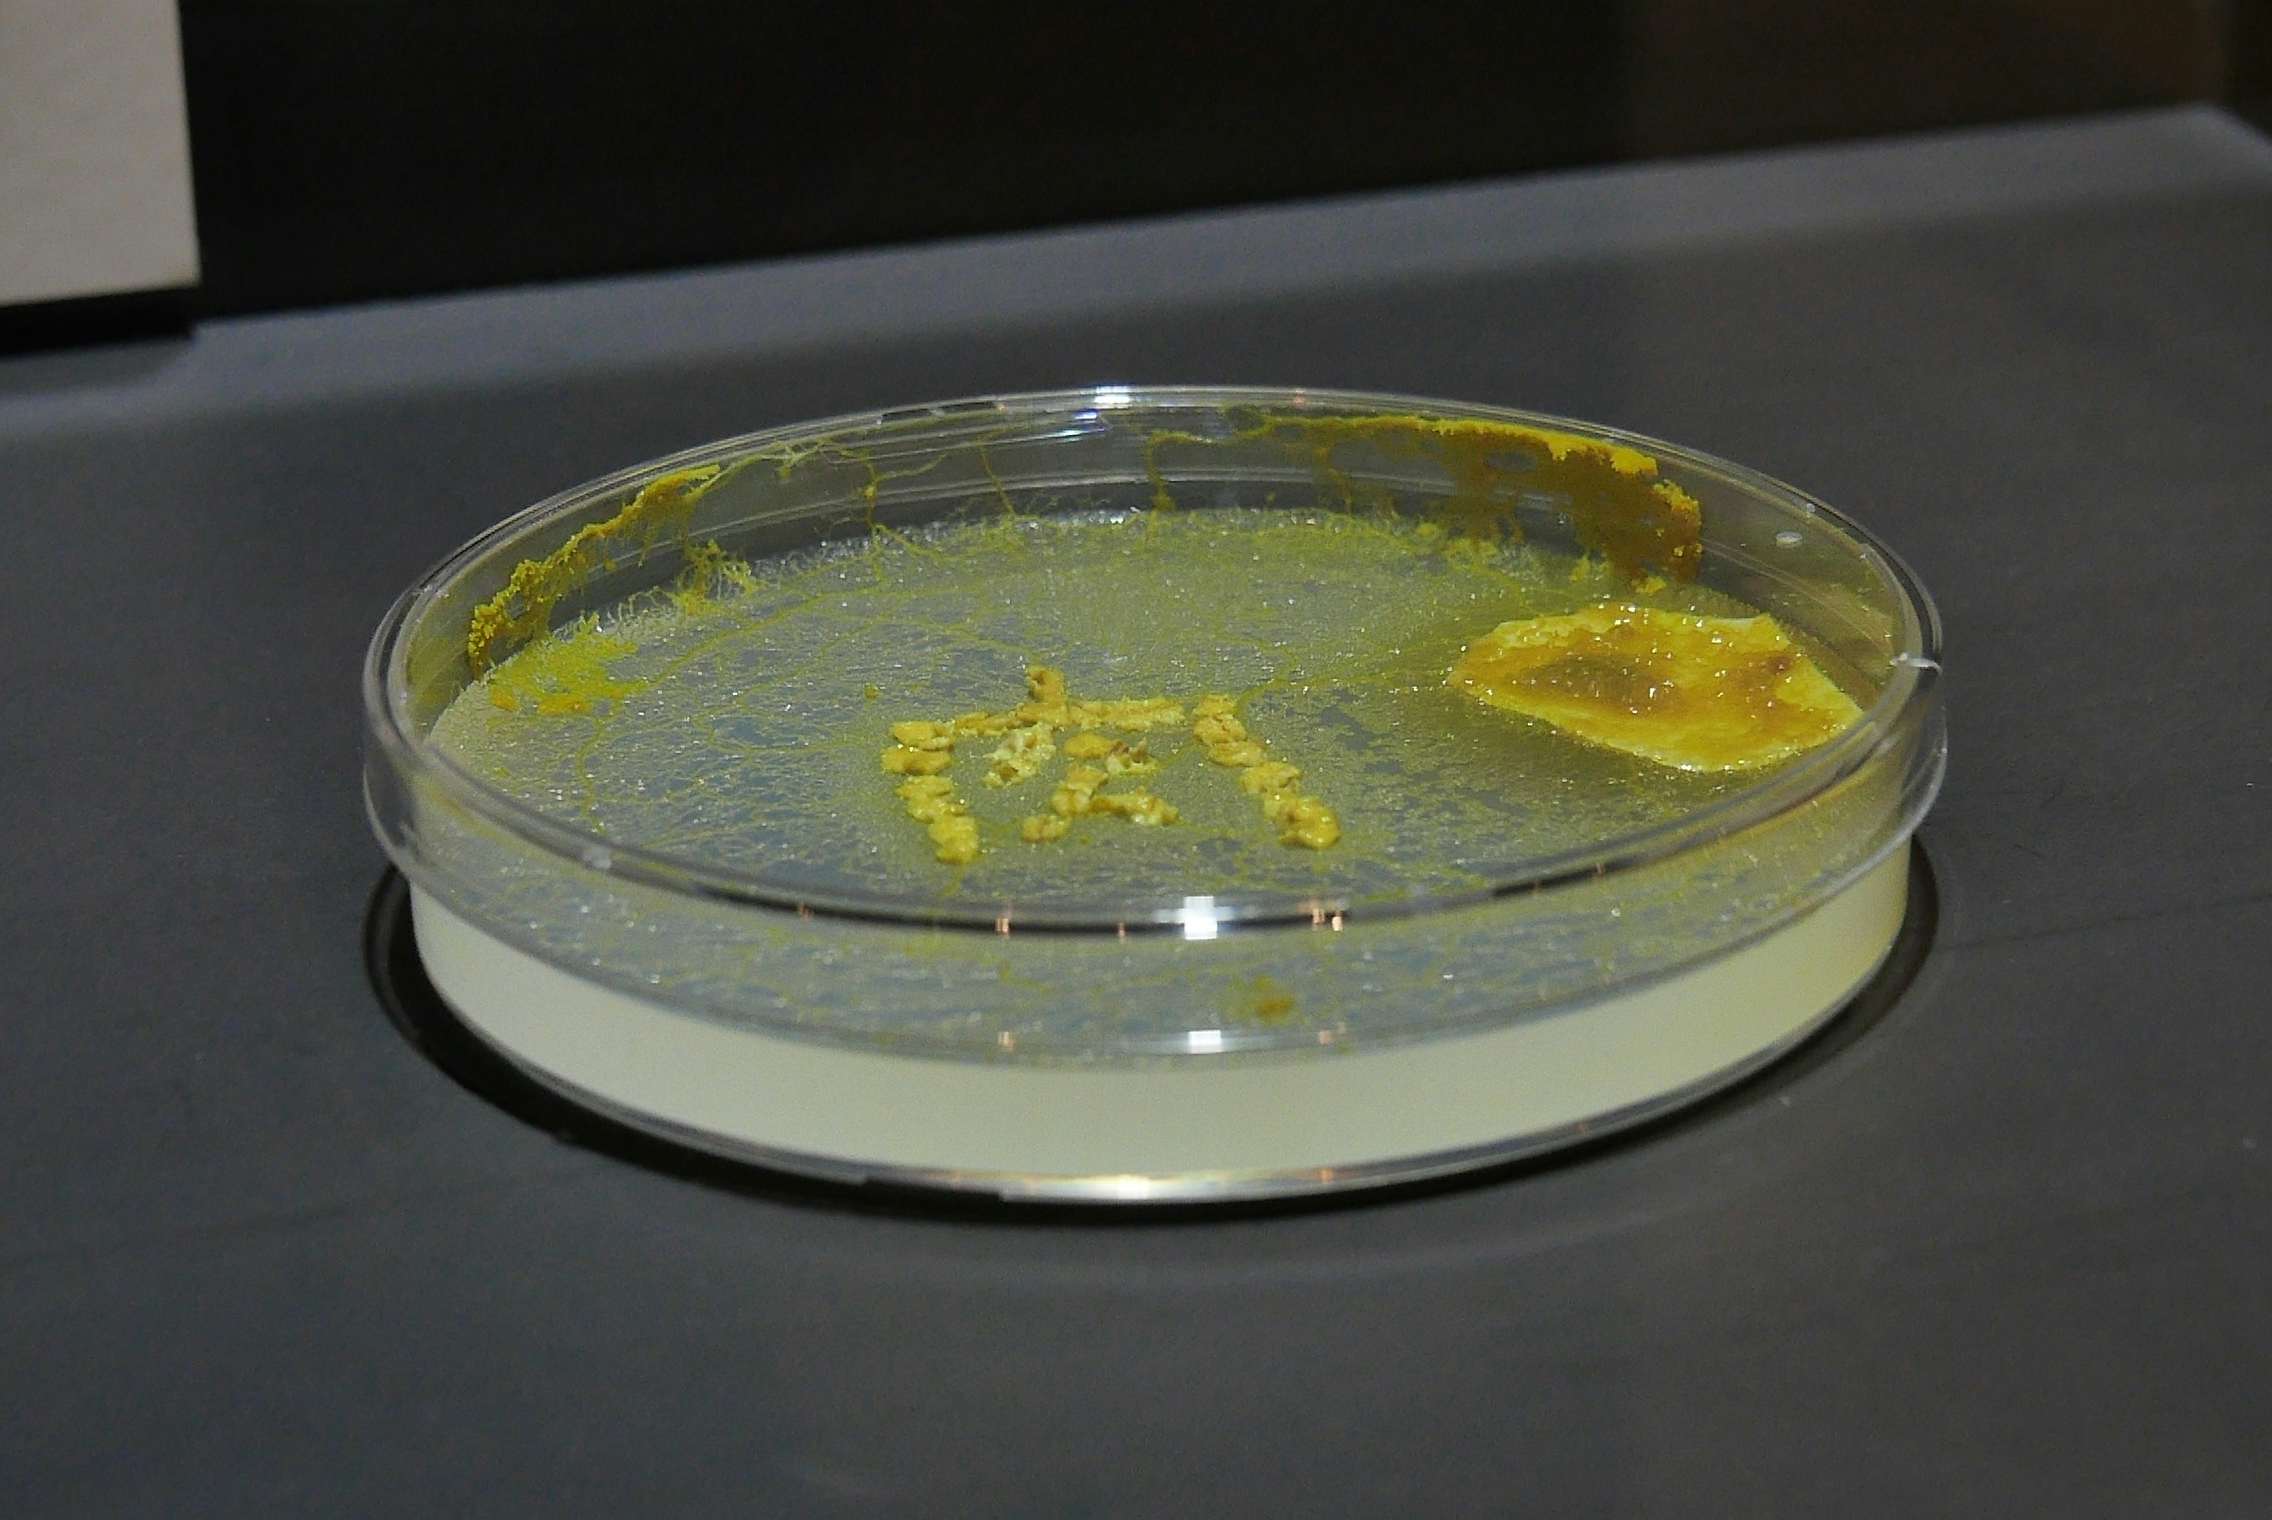

正しさからの逃げみちを探して
『市原佐都子 肉の上を粘菌は通った』(札幌文化芸術交流センター SCARTS)
劇作家・市原佐都子による初の展覧会が、札幌市文化芸術交流センター(以下、SCARTS)で開催された。同展はSCARTSと北海道大学科学技術コミュニケーション教育研究部門(以下、CoSTEP)の若年層向け研究教育プロジェクト「アート&サイエンスプロジェクト」(以下、A&Sプロジェクト)企画内の招聘展示として、同プロジェクトが近年取り組むプレコンセプション・ケアの主題を扱うものである。

展示は、書き下ろしモノローグ2篇から展開されたインスタレーションを筆頭に、市原の演劇作品の映像上映室、そしてA&Sプロジェクトの活動紹介コーナーという3部構成になっている。なかでも本稿では、新作部分にあたるモノローグとインスタレーションを取り上げる。
今回招聘作家として制作に取り組んだ市原は、A&Sプロジェクト側から提示されたテーマ「プレコンセプション・ケア」に対し、リサーチ前からいわく言い難い葛藤を抱えていたと吐露している。「私は妊娠・出産を個人の人生設計や健康管理の問題として捉えたくない想いが根底にずっとあった」(*1)。制作過程で葛藤の正体を模索しながら、市原はプレコンセプション・ケアのテーマにつきものの「個人単位の健康な生殖」という臨床医療的・公衆衛生的な正しさから一度離れ、妊娠・出産を手がかりに「この世界に子供を生むとはどういうことなのか、もっと大きく捉えてみた」いと構想した(*2)。

そんな市原が「存在しないものによる聞こえるはずのない声のモノローグ」(*3)として書き上げた2篇が、インスタレーション入り口手前で配布される冊子に綴じ込まれていた。バースストライキの結果生まれなかった子供が語るモノローグ「ない肉」では、各駅停車の電車の規則的運行が工場然とした子の増殖を招く。その光景を目撃して飼育小屋でのふしあわせな子/肉の増殖を白昼夢に見た「お母さん」は、生まない意思を固める。電車が寒さでお母さんの具合を悪くし、小屋が暑さで子を追い詰める描写は、読者の意識を一瞬で各々自身の肌感覚へと向かわせる。いっぽう、続くモノローグ「ある肉」は、飼育小屋の牛の欠片から生成されたシャーレ内の培養肉によって語られる。感情も痛覚も持たないこの肉は、自分がいる環境の居心地をほとんど説明しない。その反面、脳がないのにしっかりモノローグを編んだり、耳がないのに自分が静かに生まれたことを知っていたりと、なかばSF的に他者の感覚と機能を経由して世界を捉え、表現しているような向きがある。
このように対照的な二篇は、知覚の内向性と外交性を切り替えるエクササイズとして読者に手渡される。たしかに市原のテクストではこれまで、語り手の心理や身体感覚が赤裸々に語られると同時に、むしろSF的な想像力によって、現在の科学技術では不可能な生殖や異種交配の特殊な現場空間の描写もまた試みられてきた。二篇はこの基礎構造をミニマルに展開したものといえよう。
モノローグからインスタレーションへの展開にあたり、「演出家」(*4)岸裕真が加わった。市原がリサーチ時に北海道大学の研究室で観察した粘菌たち。運動を通じて観測されるというその非人間的知性に、モノローグの声なき声をひき会わせ、彼らがそこで捉えたものをAIによる「粘菌の合唱」として鳴らしてみてはどうか。ない耳に声を聞かせるという市原のアイデアを、カスタムメイドのAIと共同制作を続けてきた岸が、展示室に実装した(*5)。

会場で先述の冊子を受け取ると、すぐ脇の台上に見えるのがライトアップされたシャーレ(*6)だ。中心ではオートミール粒で構成された「肉」の文字が、粘菌・モジホコリに覆われ黄色く湿っている。ここで判明するのは、シャーレ内で文字において姿を現す肉が、モノローグを語る培養肉だけではなかったことだ。シャーレの外には自分ととてもよく似た存在条件をシェアする他者がいる。ともすれば培養肉も、他者の目や耳を借りてこのことをすでに聞き及んでいるかもしれない。
カーテンをくぐり真っ暗なインスタレーション空間に入ると、床が巨大シャーレ群の映像プロジェクションで光っている。円の中では引きのばされたモジホコリの運動が高速再生され、そのスピードと気味よく連動するリズムが聞こえてくる。モノローグの文章とモジホコリの運動データ75時間分からLLM(大規模言語モデル)が歌詞と曲を生成したという、多声合唱曲だ。市原の声データをサンプリングし複数の声域へと調整した歌声が幾重にも重なって飛び出す。声なき粘菌がLLMを介し市原の声とテクストによって歌う姿に、「他者の感覚や機能を経由して世界を捉え、表現する」培養肉の原理が透ける。
数分間、合唱曲に耳を傾けていると、その歌詞の大部分が単語や言葉たらない音のかたちをしており、自然な文章らしいものがほとんど聞こえてこないことに気づく。実際、LLMの実装を担った岸は、制作用途に特化して自ら開発するLLMは基本的に動作が遅く、しばしば支離滅裂なテクストを生成すると明かしている(*7)。これまではそんなAIの文章に自ら推敲を加えて協働作品を成してきた岸だが、今回は、LLMが生成した歌詞ならぬ歌詞を人為的推敲なしに流してみせた。

その結果、粘菌の合唱曲の聴きどころは、歌詞の不完全さやリズムの途切れ、映像が示す速度との連動感といった楽曲構造のほころび、ないし外部との連携へと開かれていく。そのほころびの向こうに現れる外部や他者への通路こそが、肉の上をただ「通る」者にとって必要な足場であり、市原が描いた「肉」たちによる感覚・機能の交流を可能にするだろう。ならば生む者、生まない者、生まれてくる者こない者の各者からプレコンセプション・ケアが望まれる瞬間とは、こうした通路に居場所を与えることで、妊娠・出産という出来事がひととおりでない感性や文脈へと接続されるときなのかもしれない。それは他者の価値観が強制的に流れ込んでくる事態とは違い、主体が自ら通路に飛び込んだり隠れたりしながら、他者の知覚を試しに借りて世界を覗いてみるような事態である。粘菌の通行が暴く合唱曲構造のほころびは、「お母さん」にもその子にも、ときに必要な「正しさからの逃げみち」を示唆するだろう。
*1──市原佐都子「自分の身体への苦々しさからの解放」、札幌文化芸術交流センターSCARTS・北海道大学CoSTEP企画製作『SCARTSxCoSTEP Art&SCIENCE PROJECT BOOK 2024-2026』、札幌文化芸術交流センターSCARTS(札幌市芸術文化財団)、2026、20頁
*2──同論、同書、17頁
*3──同論、同書、19頁
*4──「今回は私〔=市原〕がテキストとコンセプトを考える劇作家で、岸さんが作品をかたちにする演出家のように感じます」。一篠亜紀枝「市原佐都子の探究」、同書、16頁
*5──市原、前掲論、同書、19頁
*6──台上でスポットライトを浴びるシャーレというこの舞台装置は、岸のアートプロジェクト《xoxo-skeleton》の展示でも、生体情報をAIに伝達するカプセルの展示空間として用いられた。「令和7年度 文化庁メディア芸術クリエイター育成支援事業 成果発表イベント『ENCOUNTERS』」、TODA HALL & CONFERENCE TOKYO、2026年2月28日~3月8日。3月1日、筆者鑑賞。
- 1
- 2